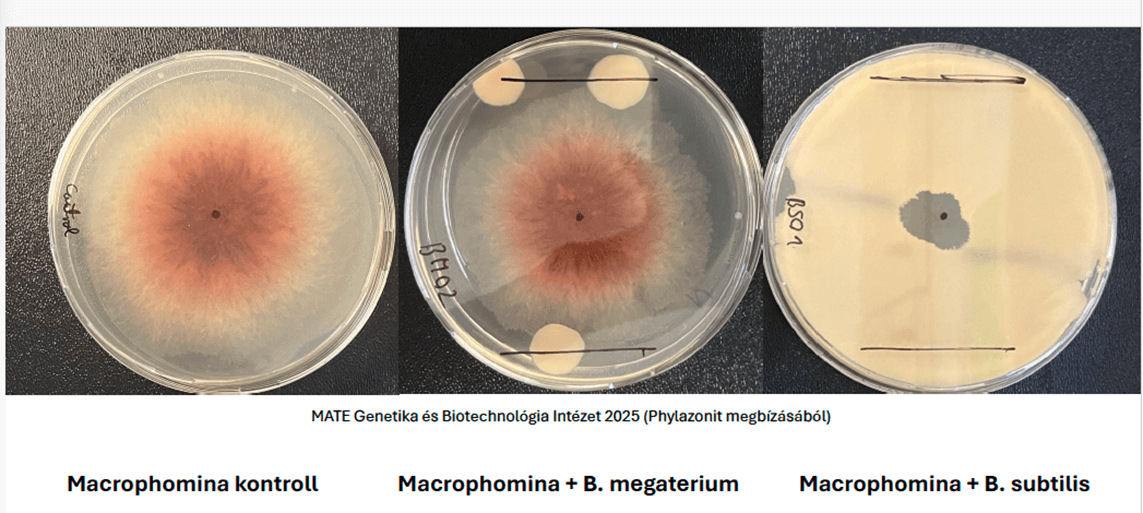

Stratégiai együttműködésünk a Magyar Agrár- és Élettudományi Egyetemmel!
A mezőgazdaság ma nem a rutinról szól, hanem a felelős döntésekről. A klímaváltozás, az erősödő kórokozói nyomás és az input költségek kiszámíthatatlansága egyértelmű üzenetet közvetít: csak az marad versenyben, aki bizonyított technológiákra épít. A Phylazonitnál ezért nem ígéretekben gondolkozunk, hanem mérésekben, adatokban és tudományos megalapozottságban.
Ennek a tudatos építkezésnek az egyik legfontosabb pillére a Magyar Agrár- és Élettudományi Egyetemmel kialakított, évek óta tartó stratégiai együttműködésünk.
Számunkra ez nem formális kapcsolat, hanem valódi, napi szintű szakmai együttműködés. Mikrobiológiai vizsgálatok, laboratóriumi és szántóföldi kísérletek, közös kísérlet beállítások, részletes kiértékelések és rendszeres szakmai egyeztetések zajlanak folyamatosan a Magyar Agrár- és Élettudományi Egyetem szakembereivel. Célunk, hogy a talajbiológiai folyamatok mögött ne csupán szakmai meggyőződés, hanem kutatói bizonyítás, mérhető adat és eredmény álljon.
A Phylazonitnál a tudományos és szakmai háttér nem kiegészítő elem, hanem a működésünk alapja. Csapatunkban ma már 11 magasan képzett, tudományos fokozattal rendelkező szakember dolgozik azon, hogy fejlesztéseink stabil, hiteles és ellenőrizhető alapokra épüljenek.

Számunkra az edukáció és az innováció kéz a kézben jár: hiszünk abban, hogy a gazdálkodók akkor tudnak felelős döntéseket hozni, ha valódi szakmai tudás áll mögöttük. A megújulás számunkra nem lehetőség, hanem kötelesség. Évről-évre új termékekkel és szolgáltatásokkal jelenünk meg a piacon. Ennek egyik idei, Magyarországon is egyedülálló eleme a szaktanácsadásba integrált talajszkenneres vizsgálati rendszer, amely helyspecifikus, precíz döntés támogatást biztosít. Emellett növényspecifikus fejlesztéseinkkel is tudatosan építkezünk folyamatosan, tavaly lucernára, idén borsóra dolgoztunk ki célzott mikrobiológiai megoldást.
Ez nem egyszerű termékfejlesztés, hanem egy mérés alapú, talajéletre épülő technológiai szemlélet következetes megvalósítása.
A 2025-ös év különösen intenzív szakmai időszak volt. A MATE Genetika és Biotechnológia Intézetében több száz közös mérés és vizsgálat valósult meg, amelyek nemcsak megerősítették az elmúlt évek fejlesztési irányait, hanem új szakmai bizonyítékokat is szolgáltattak a biológiai alapú megelőzés jelentőségére. Kiemelt fókuszba került az elmúlt években hazánkban komoly gazdasági károkat okozó macrophomina fertőzés kérdése. A piaci elvárás egyértelmű számunkra, mely szerint szükség van olyan megoldásokra, amelyek nem utólag próbálják kezelni a problémát, hanem megelőzéssel erősítik a növényt és a talajt a problémával szemben.

A laborban láthatóvá válik, ami a földben történik
A közös laboratóriumi vizsgálatok során petricsészés kísérletekben elemeztük különböző baktériumtörzsek antifungális hatását.
- Az első vizsgálati csészében kizárólag a kórokozó gomba került beoltásra, ahol a gomba zavartalan fejlődése pontosan modellezte a természetes fertőzési folyamatot.
- A második csészében olyan baktériumtörzs került a gomba mellé, amely nem rendelkezik antifungális hatással, így a gomba fejlődése ebben az esetben sem ütközött akadályba.
- A harmadik vizsgálati elrendezésben azonban egy bacillus subtilis törzs is beoltásra került, amely a Phylazonit Rizo készítményünkben is megtalálható. Az eredmény egyértelmű látható, a gomba növekedése megállt, jól látható védelmi zónák alakultak ki, a baktérium aktívan visszaszorította a kórokozó terjedését.
Ez az eredmény számunkra nem pusztán egy látványos labor fotó. Azt bizonyítja, hogy a megelőzésre épülő mikrobiológiai szemlélet tudományosan igazolható módon képes csökkenteni a kórokozói nyomást. A talajélet tudatos támogatása tehát nem elméleti lehetőség, hanem mérhető, biológiailag működő folyamat.
A MATE-val végzett közös munka biztosítja, hogy fejlesztéseink szakmailag megalapozottak, ellenőrizhetők és a gyakorlatban is alkalmazhatók legyenek. A laboreredményekből technológiai ajánlások születnek, a mérési adatokból pedig olyan döntési alap, amely valódi termelési biztonságot ad a gazdálkodók számára.
Büszkék vagyunk arra, hogy több jelentős kutatóval, kutatóintézettel és egyetemmel állunk kapcsolatban, de a Magyar Agrár- és Élettudományi Egyetemmel való együttműködésünk kiemelt stratégiai értéket képvisel számunkra.
A Phylazonitnál hisszük, hogy a jövő mezőgazdasága tudásra épül. Olyan tudásra, amely mögött mérés, kutatás és szakmai felelősség áll. Amikor a tudomány és a gyakorlat találkozik, abból születik meg az a biztonság, amelyre ma minden gazdálkodónak szüksége van.




